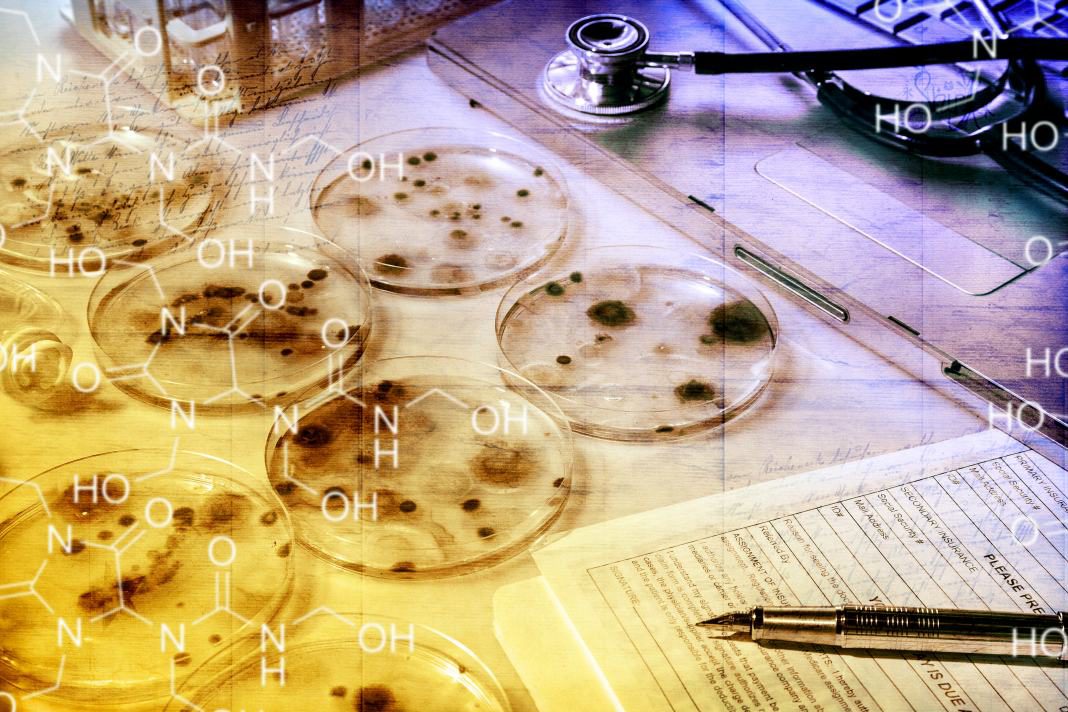

Ketoconazole is an azole medication used to treat a broad spectrum of fungi It was originally developed in the late 1970’s in the oral form and granted FDA acceptance in 1981. Shortly after the topical formulations were undergoing trials and proven effective.
The 2% cream and 1% shampoo are now available over the counter. It is effective against yeasts and dermatophytes, both systemically and topically. It is now mainly used systemically in treating life-threatening fungal infections.
Trade Name:
- Nizoral* Janssen
Dosage Forms:
- Topical: Cream: Ketoconazole cream 2% Nizoral*
- Shampoo: Ketoconazole shampoo 1% and 2% Nizoral Shampoo*
- Oral: Tablets: Ketoconazole tablets 200 mg
- Suspension: Ketoconazole oral suspension 100mg/5mL Nizoral*
Uses
| Labeled Indications | Off-Label Uses |
Topical
Systemic Tinea corporis, cruris, pedis, severe and unresponsive to Griseofulvin therapy.
Other (selection)
| Systemic
|
# – not included in Canadian product labeling
Therapeutic Regimen
| Adult | Pediatric |
Systemic
Other antifungal indications Ketoconazole 200-400mg po daily.
Topical
Seborrehic dermatitis
Pityriasis versicolor
Tinea corporis, cruris, pedis and cutaneous candidiasis
| Systemic
> 2 years of age
Vulvovaginal candidiasis
Paronychia
Topical
|
Safety Information
- Concurrent use with cisapride, aztemizole and terfenadine is contraindicated.
- Ketoconazole cream contains sulfites to which some patients may be allergic.
- Hepatotoxicity may occur and has led to reported deaths.
- Ketoconazole may increase serum digoxin concentrations and lead to toxicity.
Side Effects
- Local cutaneous effects may include itching, stinging, irritation or contact dermatitis.
- Cutaneous effects may include hypersensitivity reactions including exfoliative dermatitis and Stevens-Johnson syndrome.
- Gastrointestinal effects may include nausea, abdominal pain, diarrhea, constipation, loss of appetite and rarely, hepatotoxicity.
- Hematologic effects may include agranulocytosis or thrombocytopenia.
- Other effects may include headache, dizziness and drowsiness. Azospermia, impotence, decreased libido in menstrual irregularities may occur as a result of corticosteroid and testosterone suppression.
FDA Pregnancy Category C
Animal studies have shown teratogenicity and embryonic toxicity when given very high oral doses. Use of ketoconazole is not recommended during pregnancy or lactation.
Mechanism of Action / Pharmacokinetics
The azole antifungals interfere with cytochome P450 enzyme activity and inhibit demethylization of 14-alpha-methylsterolsterols to ergosterol. Since ergosterol is essential to the fungal cell membrane, when it is depleted the fungal cells are destroyed. Ketoconazole may also interfere with the conversion of lanosterol to cholesterol, affecting steroid hormone synthesis. Systemic ketoconazole is well distributed, however it does not penetrate the CSF. Topical application does not result in significant systemic absorption.